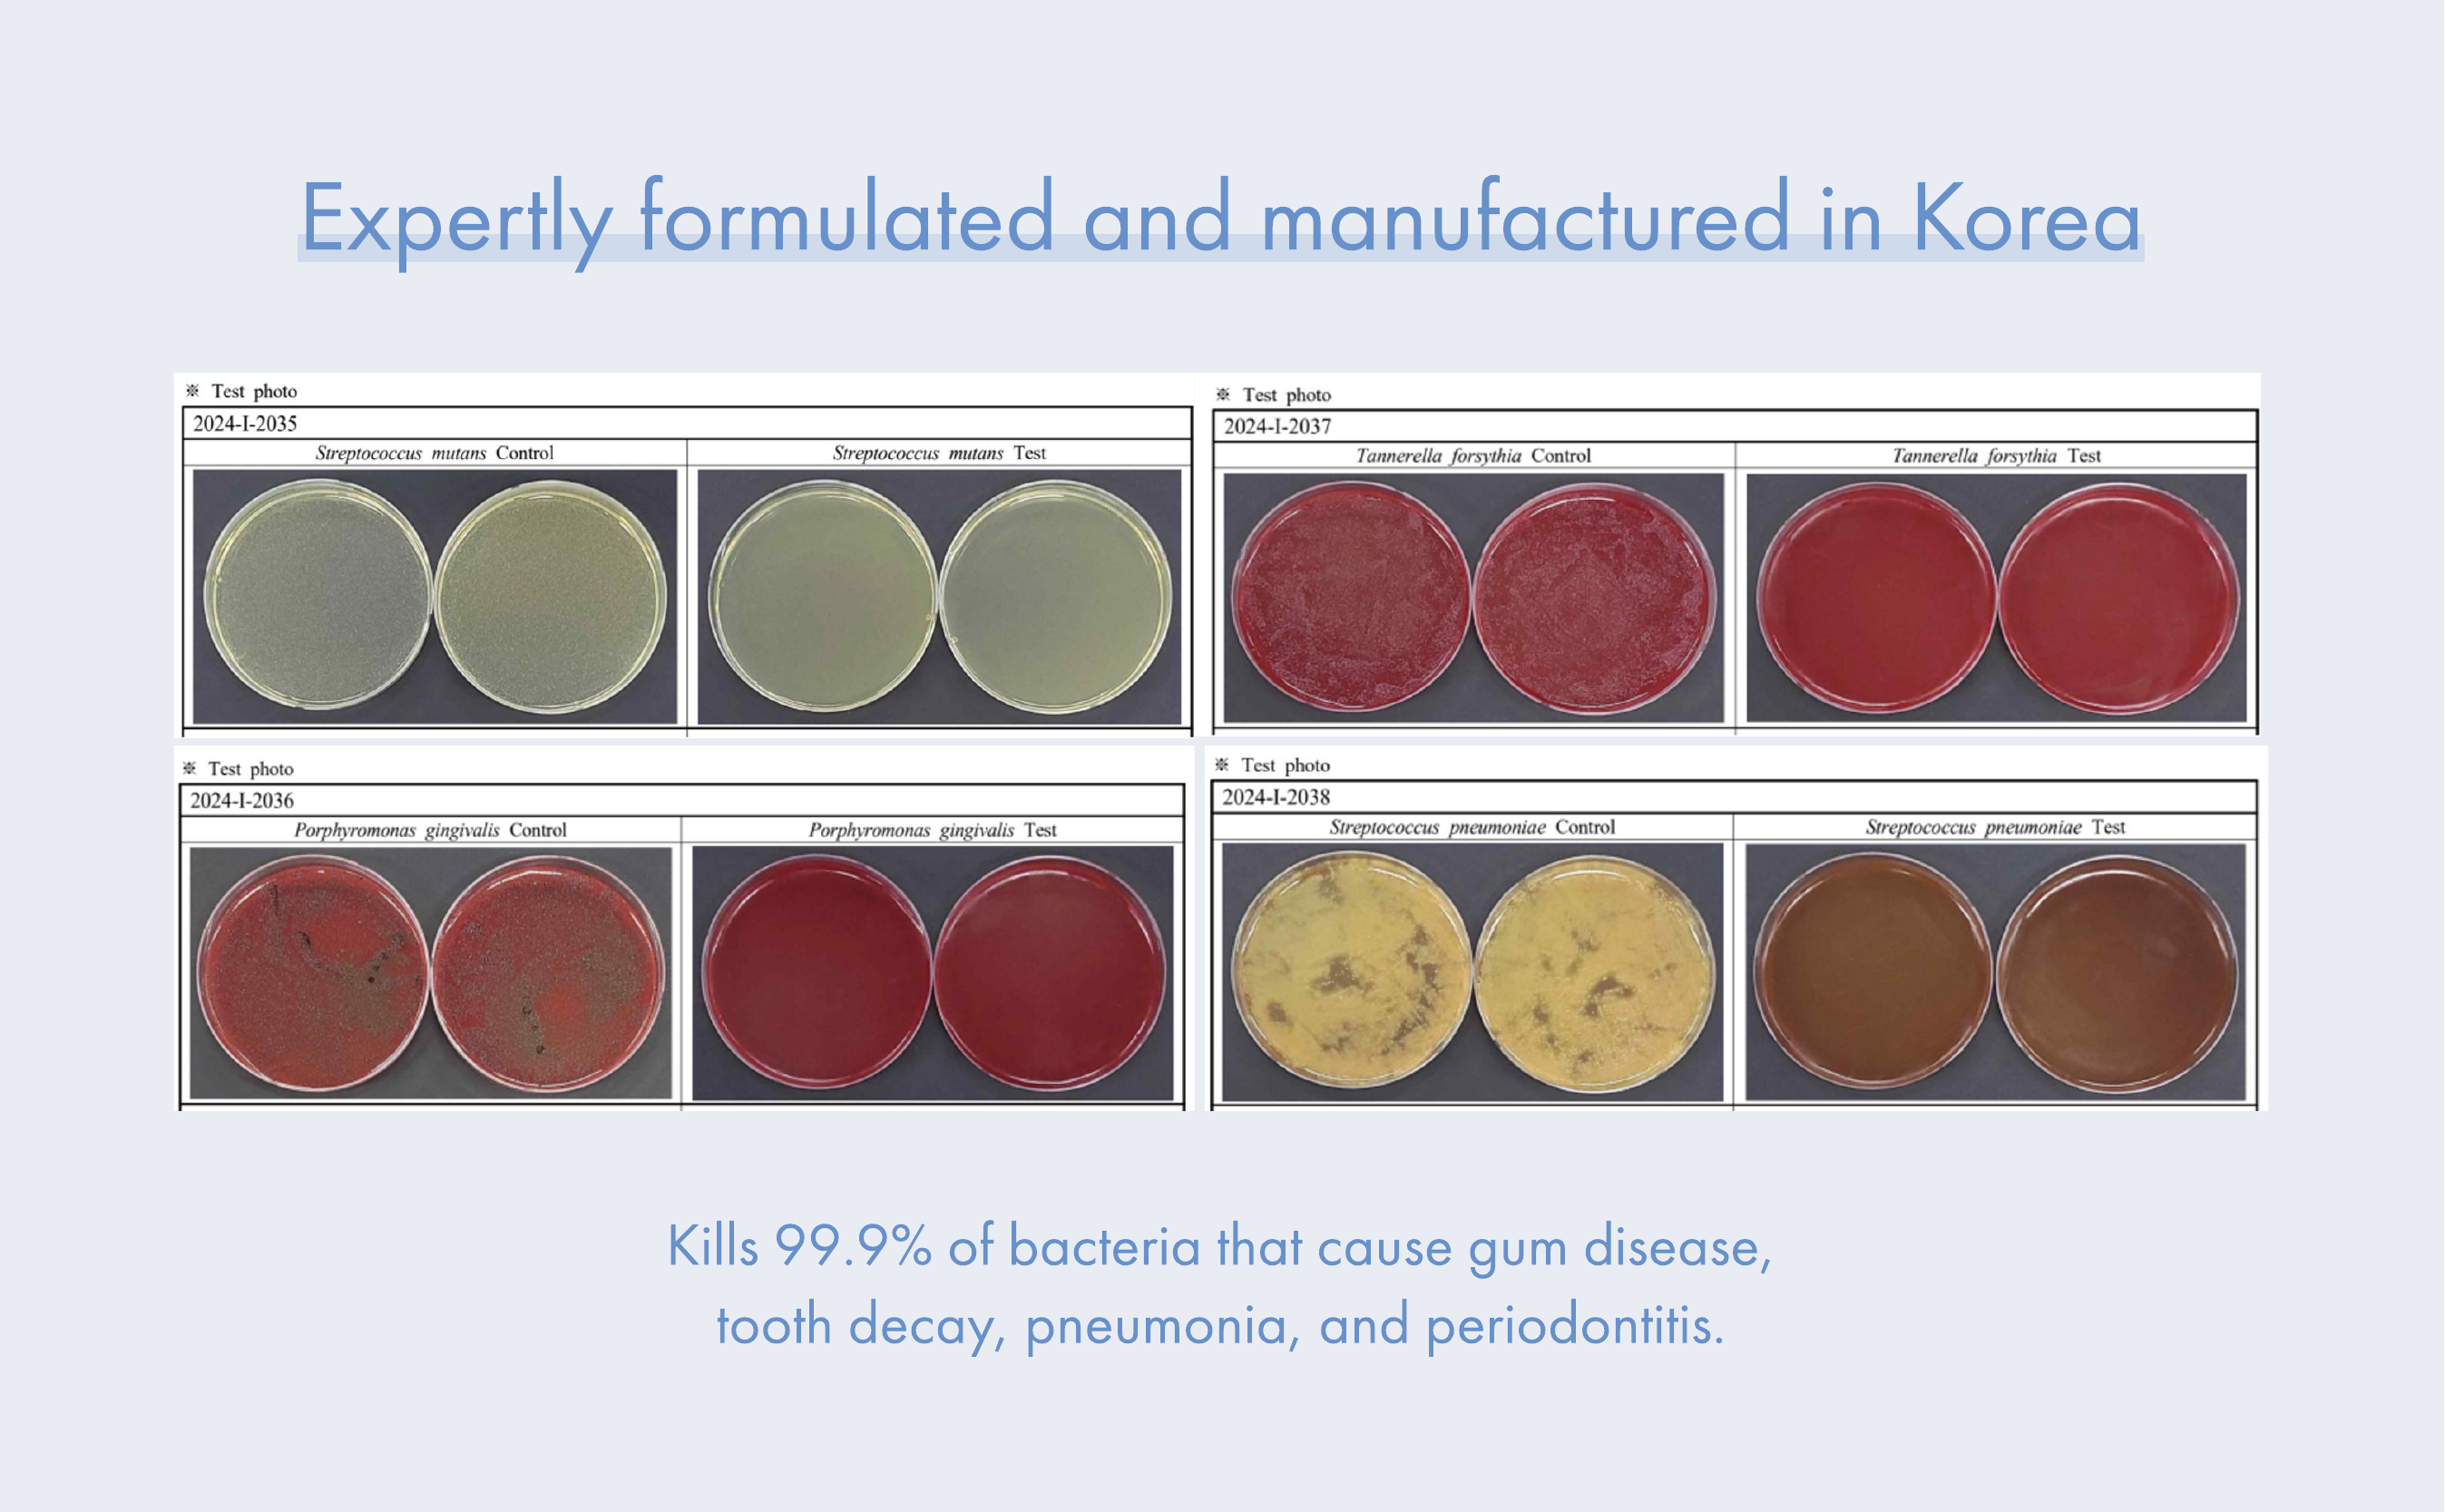

Nice colour, will look up for good buy.
It is very comfortable to wear in Singapore and unique pattern. Not that cheap but worth to pay for such material.
Clean and very hydrating
Skin glow
Great fit. Length and style is just right for me. Love the star and unusual light blueish grey colour.
Nice blouse, importantly, customer experience was great!
👍 Great
Love the crop cut fir my dance class. Good comfort fit.
The fit was perfect for me. Not too tight. Length was good for my petite height.
I like the short length. Just right for my dance class. Good quality 100% cotton.
Love the shirt! You may think it is another demin shirt but it is not! The details on the shirt made all the difference! Wear it on its own or wear it as a jacket. Good for Singapore weather!
Love it! So comfortable for our weather . Yet soft n Flowy
This korean clothing is my favorite in Singapore. It has awesome clothes with very 'in' designs..
Still haven’t worn the spooky jacket, but Jeje’s Korean fashion style never fails to bring out the best look.
Haven't worn it yet, too cold in New Zealand
Well cut and looks expensive, yet classic and slimming.
Love the soft linen texture, falls nicely on your body.
Only wore three times the front side is starting to fray here and there.
Love the trousers - its so comfortable! The checkered fabric looks great too.- Easy to pair and so versatile!
This is hands-down my favourite tee. Nice cutting and comfortable material.